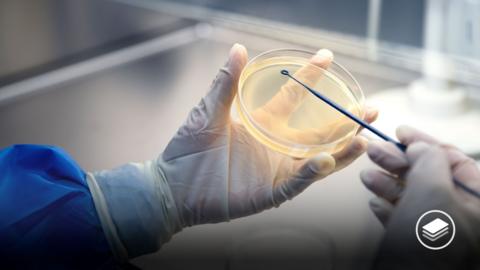
A photograph of a gloved hand holding a petri dish.

Flashcards
Enhance your revision with GCSE flashcards. These interactive flashcards, crafted with the support of subject specialists, can help you to learn and strengthen your understanding of key terms, core concepts, and important quotes.
Part ofLearn